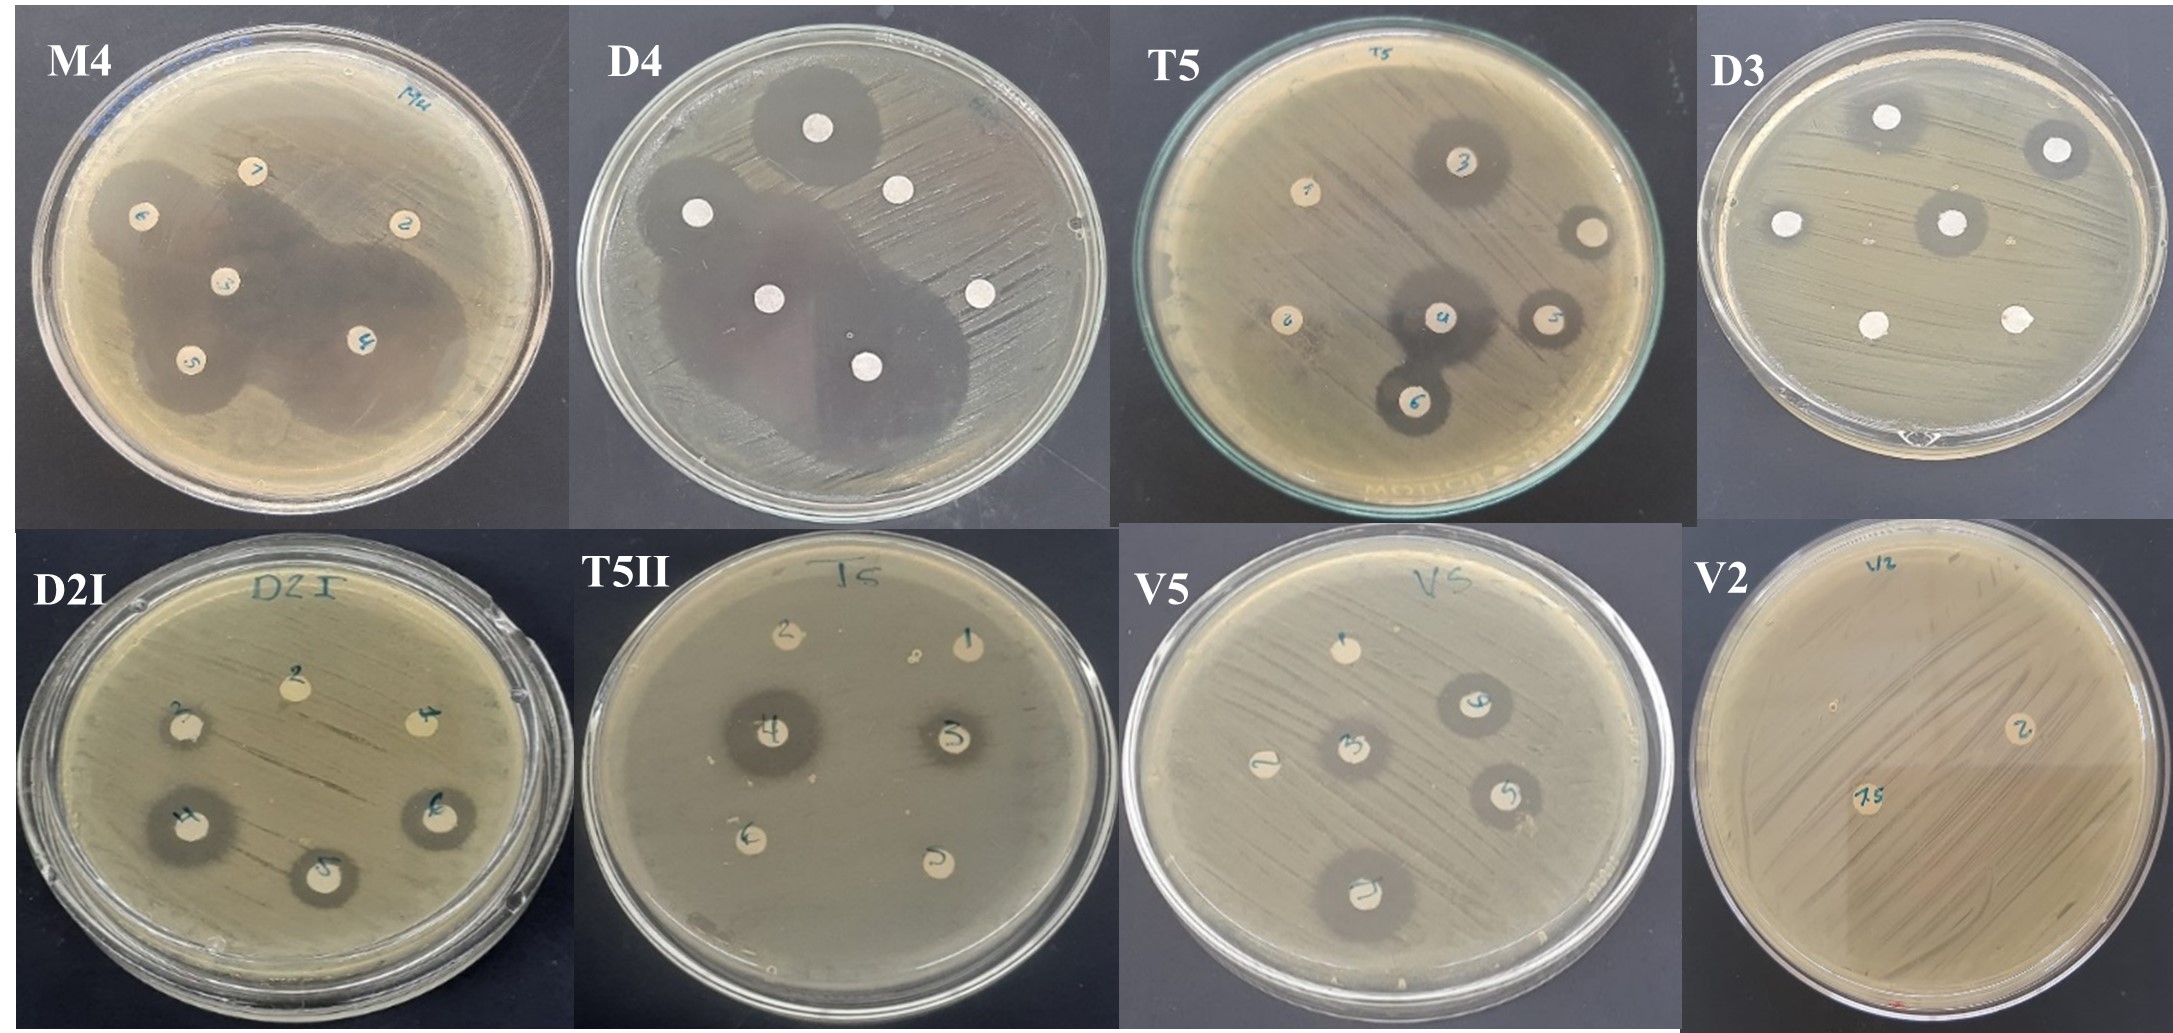
Aislados de Burkholderia gladiolii y
Burkholderia plantarii en medios de cultivo Mueller-Hinton.

Ciencia de las plantas
Identificación fenotípica de mecanismo de resistencia de las bacterias Burkholderia gladiolii y Burkholderia plantarii y sensibilidad in vitro a bactericidas de uso agrícola
Phenotypic identification of the resistance mechanism of Burkholderia gladiolii and Burkholderia plantarii bacteria and in vitro sensitivity to bactericides for agricultural use
La Calera
Universidad Nacional Agraria, Nicaragua
ISSN: 1998-7846
ISSN-e: 1998-8850
Periodicidad: Semestral
vol. 23, núm. 41, 2023
Recepción: 03 Abril 2023
Aprobación: 09 Agosto 2023

Resumen: Las bacterias Burkholderia glumae, Burkholderia gladiolii . Burkholderia plantarii son importantes en el cultivo de arroz, por provocar manchado y tizón del grano. El objetivo de esta investigación fue identificar fenotípicamente mecanismos de resistencia de B. gladiolii, B. plantarii y sensibilidad in vitro a bactericidas de uso agrícola. Los aislados bacterianos de B. gladiolii . B. plantarii fueron proporcionados por el laboratorio de Microbiología Vegetal de la Universidad Nacional Agraria, Nicaragua. La identificación de mecanismo de resistencia y sensibilidad a bactericidas de uso agrícola se realizó por el método de Bauer –Kirby (difusión en agar), se midió el tamaño de los halos de inhibición, se observó el tamaño y forma de los halos de inhibición producidos por la sinergia entre los discos de antibióticos. Se identificaron seis aislados con mecanismo de resistencia AmpC derreprimida, de estos, cuatro fueron de B. gladiolii y dos de B. plantarii; se identificó un aislado multirresistente con presencia de AmpC y cinco que no manifestaron mecanismos de resistencia. Los aislados bacterianos de Burkholderia gladiolii (D4 y M4) fueron sensibles al ácido oxolínico en comparación con los aislados (V5, D2I, V2, T5 y D3) y el aislados de B. plantarii (T5II). El aislado M4 de B. gladiolii fue susceptible al ácido oxolínico más gentamicina, mientras que los aislados de Burkholderia gladiolii (D4, D2I y D3) y el aislado de Burkholderia plantarii (T5II) fueron poco susceptible, a diferencia de los aislado bacteriano de B. gladiolii (T5 y V2) que no mostraron sensibilidad a dicho producto comercial. La dosis comercial 1.5 kg ha-1 de ácido oxolínico inhibió el mayor número de aislados en comparación con la dosis 1 kg ha-1. El producto biológico a base de Bacillus subtillis y el producto formulado sulfato de estreptomicina más oxitetraciclina no ejercieron efecto inhibitorio sobre los aislados de Burkholderia gladiolii y Burkholderia plantarii.
Palabras clave: difusión, antibióticos, AmpC, Beta-lactamasas, carbapenemasas, aislados.
Abstract: The bacteria Burkholderia glumae, Burkholderia gladiolii and Burkholderia plantarii are important in rice cultivation, for causing spotting and grain blight. The objective of this research was to phenotypically identify resistance mechanisms of B. gladiolii, B. plantarii and in vitro sensitivity to bactericides for agricultural use. Bacterial isolates of B. gladiolii and B. plantarii were provided by the Plant Microbiology Laboratory of the National Agrarian University, Nicaragua. The identification of the mechanism of resistance and sensitivity to bactericides for agricultural use was carried out by the Bauer-Kirby method (agar diffusion), the size of the inhibition halos was measured, the size and shape of the inhibition halos produced were observed by the synergy between the antibiotic disks. Six isolates with derepressed AmpC resistance mechanism were identified, of these, four were from B. gladiolii and two from .. plantarii; One multiresistant isolate with the presence of AmpC and five that did not show resistance mechanisms were identified. The Burkholderia gladiolii bacterial isolates (D4 and M4) were sensitive to oxolinic acid compared to the isolates (V5, D2I, V2, T5 and D3) and the .. plantarii isolates (T5II). The M4 isolate of .. gladiolii was susceptible to oxolinic acid plus gentamicin, while the isolates of Burkholderia gladiolii (D4, D2I and D3) and the isolate of Burkholderia plantarii (T5II) were not very susceptible, unlike the bacterial isolates of .. gladiolii (T5 and V2) that did not show sensitivity to said commercial product. The 1.5 kg ha-1 commercial dose of oxolinic acid inhibited the highest number of isolates compared to the 1 kg ha-1 dose. The biologic product based on Bacillus subtillis and the formulated product streptomycin sulfate plus oxytetracycline had no inhibitory effect on Burkholderia gladiolii and Burkholderia plantarii isolates.
Keywords: diffusion, antibiotics, AmpC, Beta-lactamases, carbapenemases, isolates.
El cultivo de arroz (Oryza sativa L.) pertenece a la familia de las gramíneas y se caracteriza por ser uno de los principales granos básicos de mayor importancia en el mundo generando un alto valor socioeconómico de cada país, como también un excelente y valioso aporte para el consumo interno de la población. (González, 2016).
En Nicaragua la producción de arroz representa el 11% del PIB agrícola nacional. Existen actualmente productores que cultivan 97 284 hectáreas, 60 % se da en condiciones de secano y un 40 % en riego con mayor tecnología. Estos productores de arroz generan unos 30 000 empleos anuales (Aguilar, 2017).
Lombeida et al. (2016) argumenta que el cultivo arroz se ve afectado por factores que limitan a la producción estos pueden ser la temperatura, humedad, velocidad del viento, suelos compactos y escases de agua y, por otra parte, están los originados por insectos, hongos, virus, nematodos y bacterias, que dificultan el manejo agronómico.
Giona-Cerezo et al. (2020) describen que la resistencia antimicrobiana se define como la capacidad de una bacteria que posee en su material genético para resistir los efectos de diferentes antibióticos, siendo una característica inherente de la bacteria o puede ser una capacidad adquirida durante el proceso infeccioso.
La resistencia a los antimicrobianos es un problema continuo y en aumento. Se hace aun mayor cuando un microorganismo presenta uno o más mecanismos de resistencias, teniendo la capacidad de transmitirlo, no sólo a su descendencia, sino también a otras bacterias de su misma o distintas especies, presentando diferentes mecanismos de resistencia como en el caso de las enzimas hidrolíticas, la modificación del sitio activo, la proteína de unión a la penicilina (PBP), modificación ribosomal, disminución de la permeabilidad de la pared celular al ingreso del antimicrobiano y la bomba de flujos (Moreno et al., 2009)
En los últimos años algunas especies como B. gladiolii (añublo del arroz) y B. plantarii (tizón de las plántulas), han venido ocasionando un impacto negativo en la producción de arroz. Ambas especies generan grandes pérdidas económicas anuales en los países productores de arroz, debido al conocimiento de los productores respecto a su detección temprana, prevención y manejo de la enfermedad (Pedraza, 2012). El manejo de B. gladiolii y B. plantarii, es cada vez más difícil de manejar, por lo que se han venido planteando diferentes estudios y estrategias con el objetivo de resolver los problemas originados por estas bacterias que afectan en gran escala al cultivo; una de estas prácticas de manejo es el uso de productos químicos que ejercen gran control contra estas enfermedades, pero en algunos casos se han encontrados bacterias que han desarrollado resistencia a diferentes formulaciones químicas (Ochi et al., 2017). El objetivo de esta investigación es fue identificar fenotípicamente mecanismos de resistencia de B. gladiolii, B. plantarii y sensibilidad in vitro a bactericidas de uso agrícola.
MATERIALES Y MÉTODOS
Ubicación del estudio
Este estudio se realizó en el laboratorio de Microbiología Vegetal del departamento de Protección Agrícola y Forestal de la Universidad Nacional Agraria en Managua, Nicaragua, ubicado en el km 12 1/2 Carretera Norte en las coordenadas geográficas 12º08'53.24" de latitud Norte y 83º09'51.24" de longitud Oeste.
Obtención del material biológico
Los aislados bacterianos de B. gladiolii y B. plantarii fueron proporcionados por el laboratorio de Microbiología Vegetal, cumpliendo los criterios de selección tales como: formar parte del cepario del laboratorio, aislados identificados mediante pruebas bioquímicas y confirmados con la técnica PCR (Polymerase chain reaction) por sus siglas en ingles.
Diseño experimental
El estudio fue descriptivo y cuantitativo, se realizó identificación de mecanismos de resistencia inducido con antibióticos en placas Petri; en el caso de las pruebas de sensibilidad se hizo en un ambiente controlado bajo un diseño completamente al azar (DCA), se colocaron los discos de antibióticos a dosis baja y alta (según recomendaciones del fabricante) sobre la superficie de la placa con medio de cultivo. Se utilizaron cinco repeticiones por cada antibiótico y aislado bacteriano.
Identificación fenotípica de mecanismos de resistencias de B. gladiolii y B. plantarii.
La identificación de mecanismo de resistencia se realizó mediante la medición y observación visual del tamaño y forma de los halos de inhibición producida por la sinergia de los discos de antibióticos (Figura 1). Los antibióticos empleados para la prueba fueron Cefepima (FEP), ceftazidima (CAZ), Ampicilina más ácido clavulánico (AMP), Meropenem (MER), Imepenem (IMP) y el inductor EDTA (ácido etilendiaminotetraacético), según Centro Nacional de Diagnóstico y Referencia (CNDR, 2004).
Los betalactámicos de espectro extendido (BLEE) se encuentran presentes cuando se manifiesta achatamiento de halo de inhibición y sinergia en discos de ceftazidima (CAZ), Ampicilina más ácido clavulánico (AMP) y Cefepima (FEP) y ausencia si no hay achatamiento ni sinergia en discos de CAZ, AMP y FEP. En el caso de carbapenemasas se asume la presencia cuando hay achatamiento de halo de inhibición y sinergia en discos de Meropenem (MER), inductor EDTA e Imepenem (IMP) y ausencia cuando no hay achatamiento ni sinergia en discos de MER, EDTA e IMP (CNDR, 2006).

Prueba de sensibilidad in vitro a bactericidas de uso comercial
Se utilizó el método de difusión en agar que consiste en impregnar discos de papel filtro con las dosis de bactericidas comerciales (Serret-López, et al., 2021). Los bactericidas de uso agrícola fueron: ácido oxolínico, sulfato de estreptomicina más oxitetraciclina, acido oxolínico más gentamicina y Bacillus subtilis a dosis baja y alta recomendada en el producto (Cuadro 1, Figura 2).
Se consideran sensibles los aislados que no crecieron alrededor del disco impregnado con el bactericida produciendo halos de inhibición mayores de 16 mm y resistentes a los aislados bacterianos que presentaron crecimiento bacteriano alrededor del disco impregnados con el bactericida, mostrando halos de inhibición menores de 6 mm, como lo indica Clinical and Laboratory Standars Institutes (CLSI, 2014).
| Bactericidas sintéticos | Dosis g 200 L-1 de agua | |
| Mínima | Máxima | |
| Sulfato de estreptomicina + oxitetraciclina | 500 | 600 |
| Ácido oxolínico | 1000 | 1500 |
| Ácido oxolínico + gentamicina | 300 | 500 |
| Bactericida biológico | Dosis L 200 L-1 de agua | |
| Mínima | Máxima | |
| Bacillus subtilis | 1.5 L | 2.0 L |
gladiolii y Burkholderia plantarii

A: Bactericidas sintéticos, 1: Sulfato de estreptomicina más oxitetraciclina 500 g 200 L-1, 2: Sulfato de estreptomicina más oxitetraciclina 600 g 200 L-1, 3: Ácido oxolínico 1000 g 200 L-1, 4: Ácido oxolínico 1500 g 200 L-1, 5: Ácido oxolínico + gentamicina 300 ml 200 L-1, 6: Ácido oxolínico + gentamicina 500 ml 200 L-1. B: Bactericida biológico (Bacillus subtilis), 1.5: dosis 1.5 L 200 L-1 y 2: Dosis 2 L 200 L-1 de agua.
Variables evaluadas
Se evaluaron los mecanismos de resistencias mediante la observación de achatamiento de halos de inhibición y la sinergia entre discos de antibióticos y la sensibilidad a bactericidas comerciales mediante la medición del halo de inhibición producido por los discos de antibióticos frente a las bacterias. Las mediciones se realizaron a las 24 horas después de la inoculación con el uso de una regla milimétrica.
Análisis de datos
Los datos fueron organizados en una hoja de Excel de Microsoft 365 empresarial. Para determinar el número de aislados que presentaron mecanismos de resistencia, se realizó un análisis descriptivo. Para la variable sensibilidad a bactericidas de uso agrícola se realizó un análisis de varianza (Andeva) y prueba de separación de medias de Tukey con 95 % de confiabilidad usando el programa estadístico InfoStat 2020 versión libre.
RESULTADOS Y DISCUSIÓN
Identificación fenotípica de mecanismos de resistencia de B. gladiolii y B. plantarii
Se analizaron 10 aislados de B. gladiolii y dos aislados de B. plantarii. Se identificaron seis aislados con mecanismo de resistencia AmpC derreprimida, de estos, cuatro fueron de B. gladiolii (D2I, M4, D3 y V5) y dos de B. plantarii (T6 y T5II) un aislado multirresistente con presencia de AmpC (V2) y cinco que no manifestaron mecanismo de resistencia. Por otro lado, en tres aislados de B. gladiolii (D2I, V5 y V2) y dos de B. plantarii (T6 y T5 II) se identificaron cambios en la permeabilidad de la membrana externa por observarse halos de inhibición pequeños en los discos de Meropenem y halos más grandes en los discos de Imepenem.
La presencia del mecanismo AmpC fue evidente por la resistencia de la bacteria a Cefoxitina con halos menores a 14 mm; no se identificaron mecanismos por carbapenemasas por la ausencia de halos de inhibición menores a 18 mm en los discos de Imepenem y Meropenem, se descarta la posibilidad de betalactamasas de espectro extendido (BLEE) por la ausencia de halos y sinergia en los discos de ceftazidima, ampicilina más ácido clavulánico y Cefepime (Figura 3). Los cinco aislados que no manifestaron mecanismo de resistencia son considerados como fenotipos salvajes o nativos, por no presentar mecanismo de resistencia.

D: aislados finca La Doña; T: aislado centro experimental TAINIC; V: aislados finca Virginia; 2, 3, 5 y 6: número de aislado; I y II: número de placas
Seral et al. (2012) mencionan que en la mayoría de las enterobacterias que poseen el gen AmpC, este se encuentra en el cromosoma bacteriano y su expresión es de bajo nivel e inducible como respuesta a la exposición a ciertos β-lactámicos como amoxicilina, ampicilina, cefoxitina, imipenem y ácido clavulánico. El fenómeno de inducción está regulado por un operon amp que requiere la presencia del β-lactámico y al menos cinco genes (AmpC, AmpR, AmpD, AmpG, AmpE) y está íntimamente relacionado con el reciclaje del peptidoglicano. El mecanismo de inducción de la β-lactamasa AmpC depende del gen AmpR, que actúa como activador durante el proceso de inducción y como represor en condiciones normales. Los genes AmpC y AmpE codifican la síntesis de proteínas de membrana (AmpC y AmpE, respectivamente) y AmpD da lugar a una proteína soluble (AmpD) que se libera en el citoplasma.
Estudios de la secuencia nucleotídica sugieren que los genes que codifican estas enzimas plasmídicas derivan de genes AmpC cromosómicos que poseen algunos miembros de la familia Enterobacteriaceae y el género Aeromonas spp, los que han sido integrados en elementos genéticos transferibles facilitando su difusión a diferentes microorganismos.
Sousa et al. (2011) expresan que Burkholderia cepacia se caracteriza por su resistencia natural a antibióticos, debido a la capacidad de formar biopelículas y cambiar su envoltura celular para reducir la permeabilidad de la membrana, impidiendo así la entrada del antibiótico. Por otra parte, Ranjan et al. (2014) manifiestan que los mecanismos que le brindan resistencia incluyen la producción de ß-lactamasas y otras enzimas, así como la modificación de los puntos objetivo de los antibióticos.
Becka et al. (2021), menciona que los miembros del género Burkholderia son intrínsecamente resistentes a múltiples fármacos y poseen una carbapenemasa PenA y una β-lactamasa AmpC, lo que hace que el tratamiento de infecciones en humanos debidas a estas especies sea problemático.
Radice et al. (2011) manifiestan que la baja permeabilidad de la membrana externa de Burkholderia cepacia produce β-lactamasas de tipo PEN que hidrolizan cefalosporinas de primera y segunda generación que son específicas de genomoespecies que produce PCM-1 (Clase D, tipo OXA), que hidroliza con más eficiencia a Imepenem que a meropenem, por lo que presenta sensibilidad variable al antibiótico meropenem.
Segonds et al. (2009) demostraron que B. gladiolii es susceptible a piperacilina, imepenem, ciprofloxacina y aminoglucósidos y resistente a ceftazidima, cefepima o aztreonam. Por otra parte, Ruiz et al. (2022) manifiestan que B. gladiolii es resistente a la gentamicina.
Sensibilidad in vitro a bactericidas de uso comercial.
Estas pruebas se realizaron con cinco aislados de Burkholderia gladiolii con mecanismos de resistencias, dos aislados de Burkholderia gladiolii sin expresión de mecanismos de resistencias y un aislado de Burkholderia plantarii con mecanismo de resistencia (Figura 4). El análisis de varianza demostró diferencia estadística (p < 0.0001) entre los aislados que fueron expuestos al ácido oxolínico; la prueba de separación de medias indicó que los aislados D4 y M4 fueron sensibles al ácido oxolínico por presentar halos de inhibición mayores a 38 mm, en comparación con los aislados T5, T5II, V5, D2I, V2 y D3 que mostraron halos de inhibición menores a 16 mm (Figura 5).
M: Agrícola Miramontes; D: aislados finca La Doña; T: aislado centro experimental TAINIC; V: aislados finca Virginia; 2, 3, 4 y 5: número de aislado; I y II: número de placas.

En relación con las dosis de ácido oxolínico el ANDEVA mostro diferencia estadística (p=0.0001) y la prueba de separación de medias indica que la dosis comercial de 1.5 kg ha-1 inhibe el mayor número de aislados en comparación a la dosis comercial de 1 kg ha-1 (Figura 6).

Los aislados que fueron expuestos a ácido oxolínico más gentamicina, presentan diferencias significativas (p<0.0001) siendo el aislados M4 el más susceptible al bactericida, mientras que los aislados V5, T5II, D3, D2I, D4 T5 y V2 no mostraron sensibilidad a dicho producto comercial (Figura 7). No se registra diferencia estadística (p=0.2970) en las dosis comerciales de 300 ml ha-1 y 500 ml ha-1. El producto biológico a base de Bacillus subtillis y el producto formulado con ingredientes activos a base de sulfato de estreptomicina más oxitetraciclina, no ejercieron efecto inhibitorio sobre los aislados de B. gladiolii y el aislado de B. plantarii.

Según Gutiérrez (2019), en un estudio realizado utilizó Ácido Oxolínico y Actybac SC Streptomyces racemochromogenes sobre el control de Burkholderia glumae, y concluyó que los bactericidas incidieron significativamente sobre control de la enfermedad que se sitúa en la panícula del arroz conocida como añublo bacteriano.
Moreira (2017) realizó pruebas de sensibilidad in vitro evaluando la eficacia de ácido oxolínico y estreptomicina más oxitetraciclina y registró que ambos bactericidas ejercieron efecto inhibitorio sobre el crecimiento de B. glumae siendo el ácido oxolínico quien presenta el mayor porcentaje de inhibición sobre las bacterias.
Valdez-Núñez (2020), manifiesta que al menos siete cepas (46.7 %) presentaron resistencia a 10 µg ml-1 de ácido oxolínico y la sensibilidad a este antibiótico fue variable, en particular para B. glumae (AMG12-06). Para el caso de aislados de B. glumae al aumentar la concentración de ácido oxolínico la mayoría de las cepas se mostraron más o menos sensibles y solo el aislado de B. gladioli (TUG05-07) pudo ser considerada como altamente resistente a este antibiótico.
Serret-López et al. (2021), demostraron que los productos ensayados cuprimicin agrícola (200 g 100 L-1), serenade polvo (1 kg 200 L-1), bactrol 2X (60 g 100 L-1), bactriomicin agrícola (400 g 100 L-1), fungifree biológico (2.5 kg 200 L-1), cuprimicin 500 (625 g 100 L-1), phyton (1.5 ml L-1), oxicloruro de cobre (400 g 100 L-1), kasumin (2 L 200 L-1), final bacter (1.6 kg 200 L-1), bacterbest biológico (1 L 200 L-1) y biotermin biológico (3 L 200 L-1) no tuvieron efecto inhibitorio sobre B. gladioli (MT672591) aislados de cebolla.
En nuestro país es el primer estudio que se realiza sobre la evaluación de sensibilidad in vitro de B. gladiolii y B. plantarii a bactericidas de uso agrícola, destacando a los aislados D4 y M4 perteneciente a B. gladiolii como sensibles al ácido oxolínico.
CONCLUSIONES
Se identificaron seis aislados con mecanismo de resistencia AmpC derreprimida, de estos, cuatro fueron de Burkholderia gladiolii y dos de Burkholderia plantarii; se identificó un aislado multirresistente con presencia de AmpC y cinco que no manifestaron mecanismo de resistencia. Los aislados D4 y M4 fueron sensibles al ácido oxolínico en comparación con los aislados T5, T5II, V5, D2I, V2 y D3. El aislado M4 de Burkholderia gladiolii fue susceptible al ácido oxolínico más gentamicina, mientras que los aislados D4, D2I, T5II, y D3 no fueron susceptible por presentar halos de inhibición menor a 16 mm, a diferencia de los aislados T5 y V2, que no mostraron sensibilidad por no mostrar halos de inhibición.
Referencias
Aguilar Bustamante, V., Méndez, C., Treminio Artola., E. y Loáisiga Vallecillo, V. L. (2017). Evaluación agronómica de nueve líneas avanzadas de arroz (Oriza sativa L.) y dos testigos comerciales bajo condiciones de riego por inundación, Sébaco, Matagalpa. La Calera, 29(17), 51-56. https://doi.org/10.5377/calera.v17i29.6524
Becka, S. A., Zeiser E., T., LiPuma J., J. & Papp-Wallace, K. M. (2021). Activity of Imipenem-Relebactam against Multidrug- and Extensively Drug-Resistant Burkholderia cepacia Complex and Burkholderia gladioli. American Society for Microbiology, 65(11), 1321-1332. https://doi.org/10.1128/AAC.01332-21
Centro Nacional de Diagnóstico y Referencia. (2004). Manual de procedimiento de Bacteriología Médica. Litonic.
Clinical and Laboratory Standars Institutes. (2014). Perfomance Standar for Antimicrobial Susceptibility Testing; Twenty-Fourth Informacional Supplemen. https://www.researchgate.net/file.PostFileLoader.html?id=59202a0696b7e4d462166956&assetKey=AS%3A496054988533760%401495280134033
Giona-Cerezo, S., Santos-Preciado, J. I., Marfin-Otero, M. R., Torrez-López, F. J. y Alcantar-Curriel, M. D. (2020). Resistencia antimicrobiana. Importancia y esfuerzo por contenerla. Gaceta Medica de México, 156, 172-180. https://doi.org/10.24875/GMM.20005624
González, B. M. y Alonso, A. M. (2016). Tecnologías para ahorrar agua en el cultivo de arroz. Nova, 14(26), 111-126. https://doi.org/10.22490/24629448.1757
Gutiérrez Lozada, D. F. y Espinosa Artunduaga, D. (2019). Evaluación de los bactericidas de oxilobac (Ácido oxolinico) y actybac sc (streptomyces racemochromogenes) para el control de la bacteria Burkholderia glumane como uno de los causantes del añublo bacteriano de la panícula del arroz (Oryza sativa) en el municipio de Campoalegre, departamento Huila [Tesis de Ingenieria, Universidad Nacional Abierta y a Distancia]. Repositorio Institucional. https://repository.unad.edu.co/bitstream/handle/10596/25407/dfgutierrezl.pdf?sequence=1&isAllowed=y
Lombeida La Rosa, A. L. y Cepeda Landin, E. W. (2016). Diseño de una metodología de evaluación preliminar para el manejo del Añublo Bacterial de la panícula del arroz en el Ecuador [Tesis de grado, Escuela Superior Politécnica del Litoral]. Repositorio de ESPOL. http://www.dspace.espol.edu.ec/handle/123456789/51706
Moreira C., R. I. (2017). Evaluación in vitro de la eficacia de bactericidas sobre la inhibición del crecimiento de Burkholderia glumae [Tesis de Licenciatura, Universidad Nacional Agraria]. Repositorio Institucional. https://repositorio.una.edu.ni/3554/1/tnh20m838.pdf
Moreno, M. C., González, E. R. y Beltrán, C. (2009). Mecanismos de resistencia antimicrobiana en patógenos respiratorios. Revista de Otorrinolaringología y Cirugía De Cabeza y Cuello, 69, 185-192. https://www.scielo.cl/pdf/orl/v69n2/art14.pdf
Ochi, A., Konishi, H., Ando, S., Sato, K., Yokoyama, K., Tsushima, S., Yoshida, S., Morikawa, T., Kaneko, T., & Takahashi, H. (2017). Management of bacterial seedling blight diseases in nurseries by irradiating rice seeds with atmosferic plasma. Plant pathology, 66, 67-76. https://doi.org/10.1111/ppa.12555
Pedraza-Herrera, L. A., Bautista, J. P., Cruz-Ramírez, C. A., & Uribe-Vélez, D. (2020). BUN2755 Bacillus strain controls seedling root and bacterial panicle blight caused by Burkholderia glumae. Biological Control, 153. 1-32. https://doi.org/10.1016/j.biocontrol.2020.104494
Radice, M., Marín, M., Giovanakis, M., Vay, C., Almuzara, M., Limansky, A., Casellas, J. M., Famiglietti, A., Quinteros, M., Bantar, C., Galas, M., Pupko, J. K., Nicola, F., Pasterán, F., Soloaga, R. y Gutkind, G. (2011). Criterios de ensayo, interpretación e informe de las pruebas de sensibilidad a los antibióticos en los bacilos gram negativos no fermentadores de importancia clínica: recomendaciones de la Subcomisión de Antimicrobianos de la Sociedad Argentina de Bacteriología, Micología y Parasitología Clínicas, Asociación Argentina de Microbiología. Revista Argentina de Microbiología, 43. 136-153. http://www.scielo.org.ar/pdf/ram/v43n2/v43n2a12.pdf
Ranjan, N., Chaudhary, U., Chaudhry, D., & Ranjan K, P. (2014). Ventilator-associated pneumonia in a tertiary care intensive care unit: Analysis of incidence, risk factors and mortalityAnalysis of incidence, risk factors and mortality. Indian Journal of Critical Care Medicine, 18(4) 200-204. https://doi.org/10.4103/0972-5229.130570
Ruiz H, E., Caro V., M. R. y Ortega H., N. (2022). Resistencia fenotípica y genotípica en los patotipos Aiec, Stec y Eaec de E. coli. Anales de Veterinaria de Murcia, 36. https://doi.org/10.6018/analesvet.540611
Serret-López, M., Aranda-Ocampo, S., Espinosa-Victoria, D., Ortiz-Martínez, L. E., & Ramírez-Razo, K. (2021). Polyphasic characterization of Burkholderia gladioli isolated from onion and evaluation of its potential pathogenicity for other crops. Mexican Journal of Phytopathology, 39. https://doi.org/10.18781/r.mex.fit.2007-2
Seral, C., Gude, M. J. y Castillo, F. J. (2012). Emergencia de β-lactamasas AmpC plasmídicas (pAmpC ó cefamicinasas): origen, importancia, detección y alternativas terapéuticas. Revista española de quimioterapia, 25(2), 89-99. https://seq.es/wp-content/uploads/2012/06/seq.es_seq_0214-3429_25_2_seral.pdf
Segonds, C., Clavel-Batut, P., Thouverez, M., Grenet, D., Coustumier A., L., Plesiat, P., & Chabanon, G. (2009). Microbiological and Epidemiological Features of Clinical Respiratory Isolates of Burkholderia gladioli. Journal of Clinical Microbiology, 47(5), 1510–1516. https://doi.org/10.1128/JCM.02489-08
Sousa, S. A., Ramos, C. G. & Leitao, J. H. (2011). Burkholderia cepacia Complex: Emerging Multihost Pathogens Equipped with a Wide Range of Virulence Factors and Determinants. International Journal of Microbiology. https://doi.org/10.1155/2011/607575
Valdes-Nuñez, R. A., Rios-Ruiz, W. F., Ormeño-Orillo, E., Torres-Chavez, E. E., & Torrez-Delgado, J. (2020). Genetic characterization of rice endophytic bacteria (Oryza sativa L.) with atimicrobial activity against Burkholderia glumae. Revista Argentina de Microbiología, 52(4), 315-327. https://doi.org/10.1016/j.ram.219.12.002
Notas de autor

